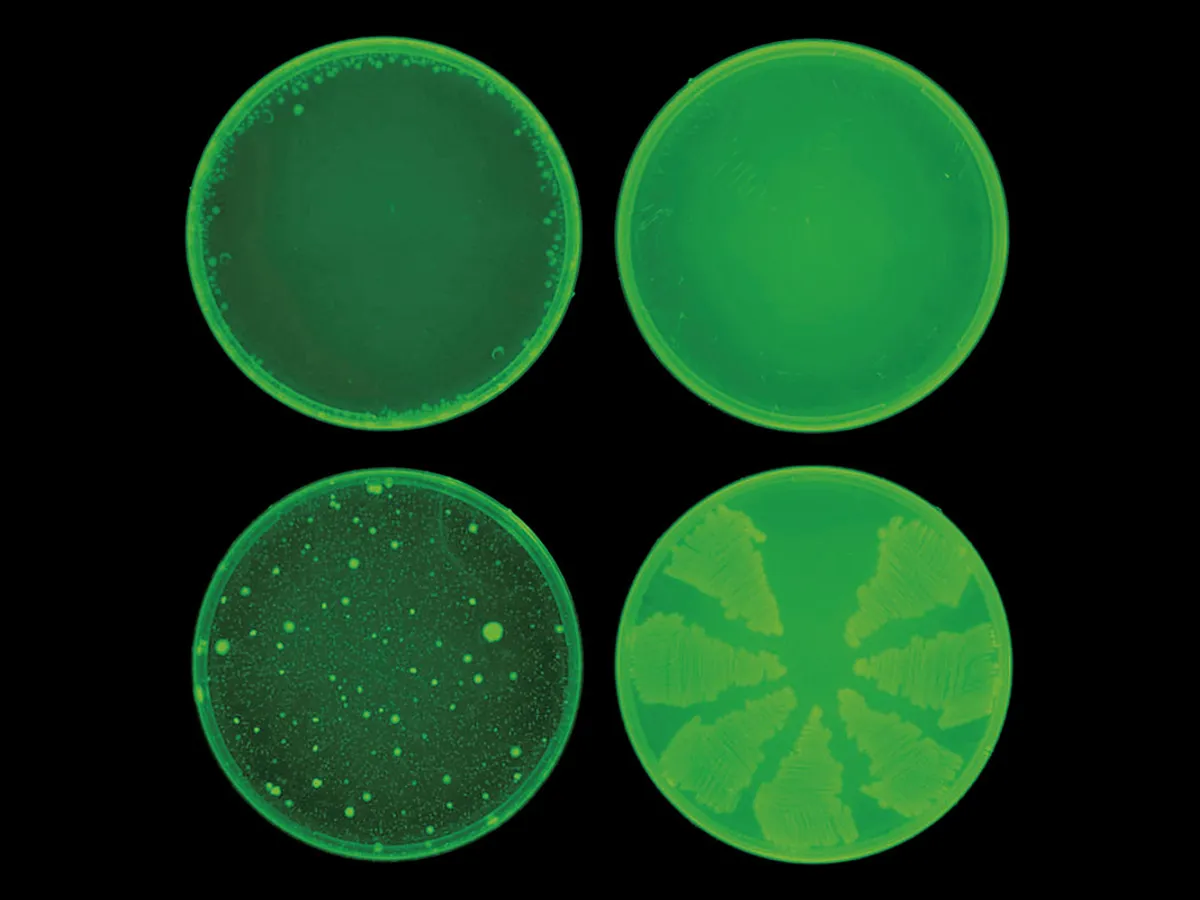

Mașinile nu clipesc. Cum schimbă inteligența artificială războaiele lumii
Data publicării: 15.12.2021 • 16:10
Data actualizării: 23.03.2026 • 15:42

Inteligența artificială (AI) a devenit omniprezentă, la nivel mic și mare. Motoarele de căutare, hărțile și rețelele sociale ne analizează istoria pentru a face predicții și a adapta răspunsuri relevante.
Aplicațiile de text și de e-mail, care cunosc cuvintele și expresiile pe care le folosim cel mai des, încearcă să ne completeze propozițiile.
Articol premium
Contribuie la susținerea jurnalismului de calitate!
Abonamente de la doar 4,17 lei pe săptămână!
Alege tipul de abonament care ți se potrivește!
Abonează-te acum!
’ Extras din „The Age of AI/Era AI” de Henry A. Kissinger, Eric Schmidt și Daniel Huttenlocher. Copyright © 2021. Disponibil de la Little, Brown & Company, editură a Hachette Book Group, Inc.




















